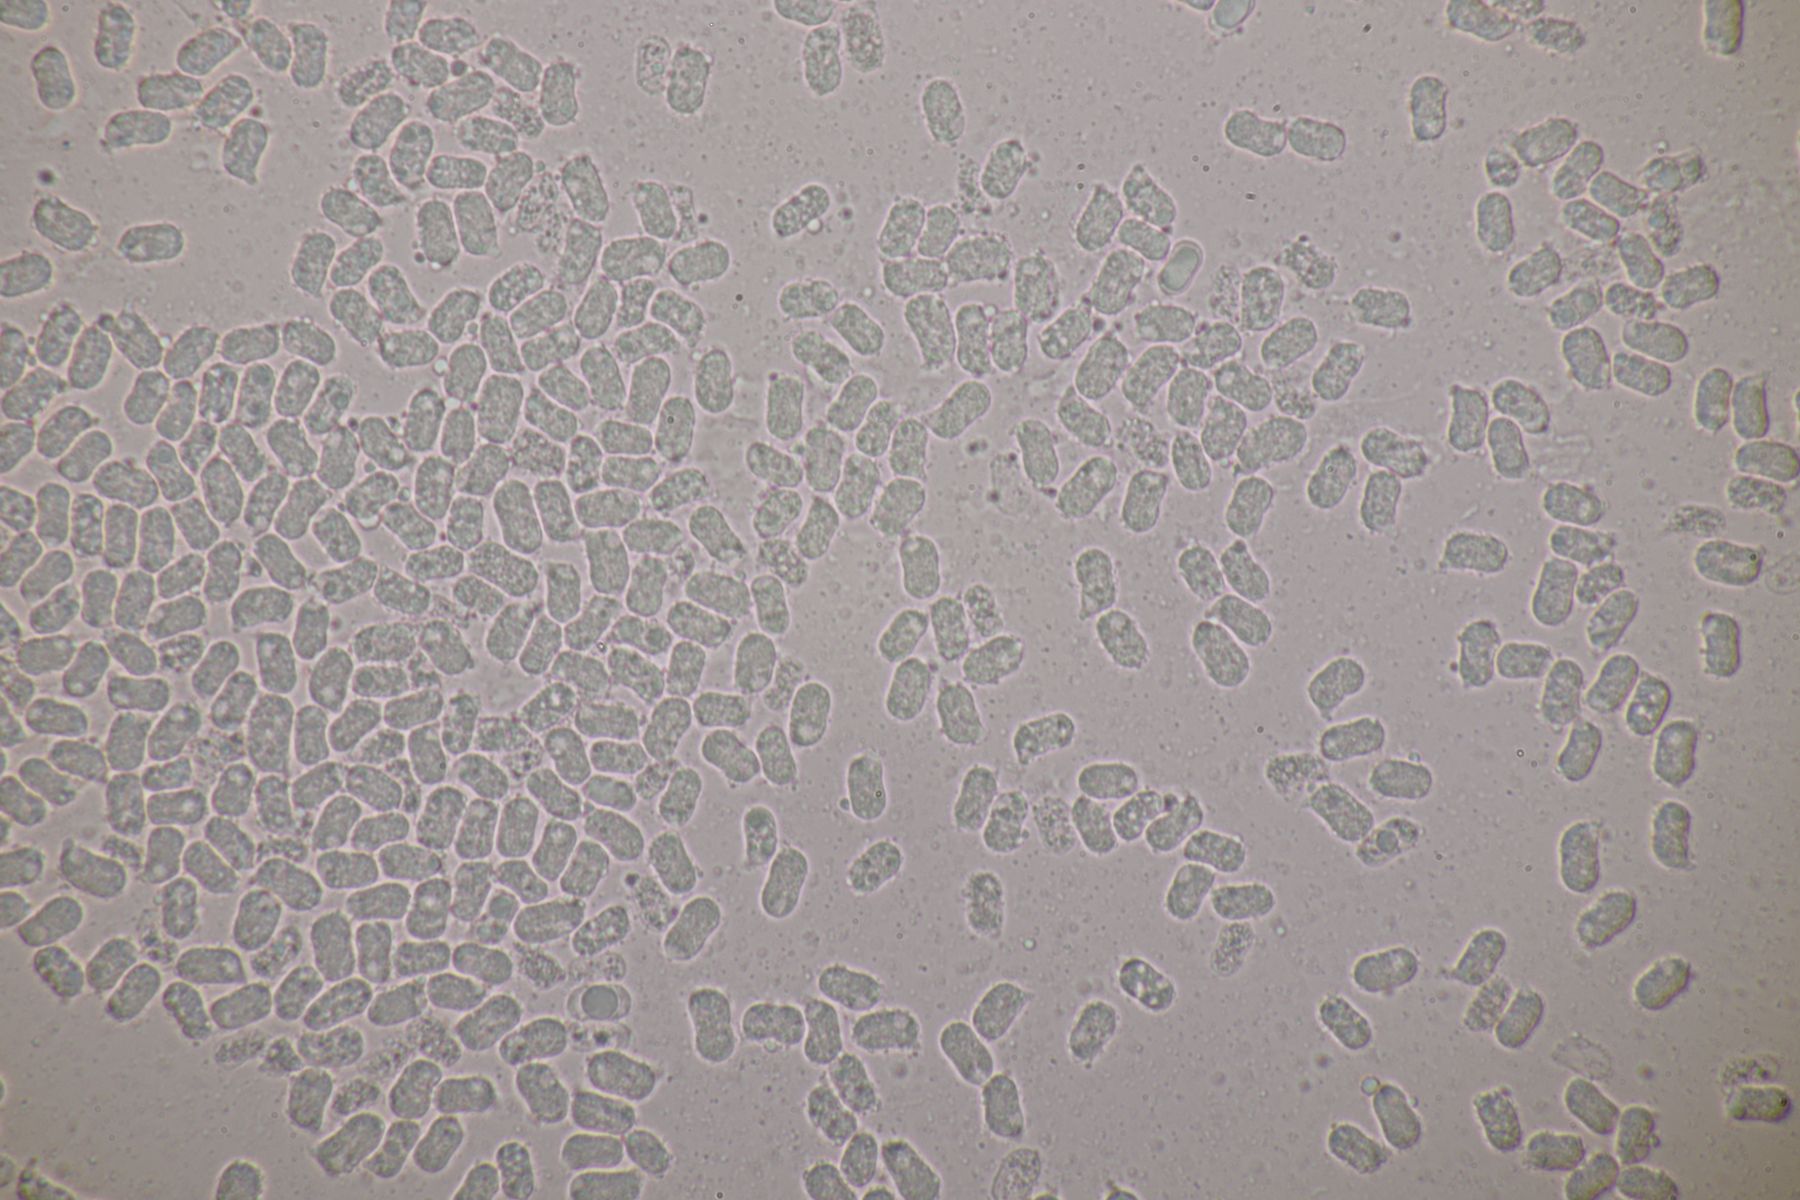

Hallo zusammen,
die meisten von Euch dürften mitbekommen haben, daß Chris wieder einmal das großartige Saftlingstreffen in Wiesbaden organisiert hat. Dafür an dieser Stelle auch noch mal ein herzliches Dankeschön! Ich habe zum ersten Mal beim Saftlingstreffen teilgenommen und bin schwer beeindruckt. 8 für mich neue Saftlingsarten an einem Tag sind schon eine Hausnummer. Auch wenn hier ja schon erste Eindrücke von dem Treffen geschildert wurden, habe ich mich entschlossen, hier noch mal einen separaten Beitrag aufzumachen, da meine Beiträge ja traditionell doch etwas mikroskoplastig sind.
1. Cuphophyllus russocoriaceus. Auch wenn ich keine Ahnung habe, wie Juchtenleder riecht, konnte ich schon einen angenehmen Geruch wahrnehmen. Sporenmaße 8,5±0,4 µm × 5,2±0,4 µm, Q=1,7±0,1; 7,8-9,7 µm × 4,4-6,3 µm, Q=1,4-2






2. Clavaria fumosa. Das erste Bild zeigt vielleicht aber auch nur einen Untoten, der es bei Halloween dann doch nicht ganz aus der Erde geschafft hat
Sporenmaße 7,1±0,4 µm × 3,4±0,2 µm, Q=2,1±0,1; 6,2-7,9 µm × 2,9-3,8 µm, Q=1,8-2,4






3. Hygrocybe citrinovirens. Sporenmaße 7,8±0,5 µm × 5,4±0,5 µm, Q=1,4±0,1; 6,7-9 µm × 4,7-6,5 µm, Q=1,2-1,7








4. Entoloma anatinum

5. Gliophorus irrigatus

6. Hygrocybe punicea

7. Neohygrocybe ovina. Bestimmt nicht der hübscheste Saftling, aber das Röten bei Berührung ist schon beeindruckend. Sporenmaße 8,6±0,9 µm × 6,5±0,6 µm, Q=1,3±0,1; 7,5-10,6 µm × 5,5-7,8 µm, Q=1,2-1,6








8. Neohygrocybe nitrata mit sehr intensivem Schwimmbadgeruch. Sporenmaße 9,1±0,4 µm × 4,7±0,3 µm, Q=1,9±0,1; 8,2-10,2 µm × 4-5,2 µm, Q=1,7-2,2







9. Hygrocybe quieta. Sporenmaße 7,8±0,3 µm × 4,4±0,3 µm, Q=1,8±0,1; 7,2-8,2 µm × 3,9-5,1 µm, Q=1,5-1,9

10. Hygrocybe splendidissima mit sehr intensivem Honiggeruch. Sporenmaße 8,4±0,4 µm × 5±0,3 µm, Q=1,7±0,1; 7,6-9,4 µm × 4,5-5,8 µm, Q=1,5-1,8







11. Riecht auch, aber nicht angenehm: Clathrus archeri

12. Eines der absoluten Highlights: Porpolomopsis calyptriformis. Sporenmaße 7,6±0,6 µm × 5,5±0,2 µm, Q=1,4±0,1; 6,7-8,8 µm × 5-5,9 µm, Q=1,2-1,5








13. Gliophorus sciophanus. Sporenmaße 7,9±0,4 µm × 5,6±0,4 µm, Q=1,4±0,1; 7-8,5 µm × 4,8-6,4 µm, Q=1,2-1,5







14. Entoloma jubatum. Sporenmaße 8,6±0,5 µm × 6,1±0,5 µm, Q=1,4±0,1; 7,6-9,8 µm × 4,8-6,9 µm, Q=1,2-1,6


15. Noch ein Entoloma, zu dem es im Feld erstmal keinen Namen gab.

16. Hygrocybe fornicata. Sporenmaße 6,1±0,3 µm × 4,1±0,3 µm, Q=1,5±0,1; 5,7-6,7 µm × 3,8-4,6 µm, Q=1,3-1,7






17. Ramariopsis robusta



18. Ein noch unbeschriebender Doppelgänger von Hygrocybe coccinea. Sporenmaße 9,3±0,7 µm × 4,2±0,3 µm, Q=2,2±0,1; 8,1-10,5 µm × 3,5-4,8 µm, Q=2-2,4








19. Contumyces rosellus

20. Hygrocybe aurantiosplendens. Sporenmaße 8,4±0,6 µm × 4,4±0,2 µm, Q=1,9±0,2; 7,6-9,6 µm × 3,8-4,7 µm, Q=1,7-2,4








Soviel erstmal zu den Wiesenpilzen des Tages. Da es vor und nach der Wiese noch etwas Zeit gab, haben wir auch ein paar tolle Pilze im Wald gefunden, die folgen dann gleich.
Björn